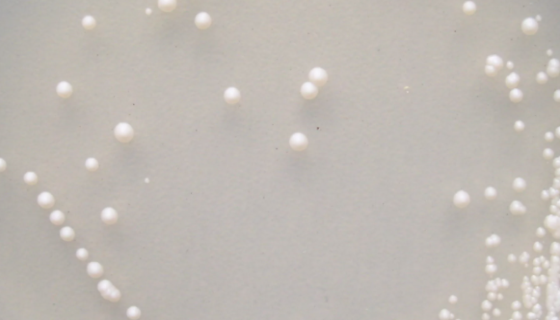
酿酒酵母的主要价值与应用方向及相关研究！
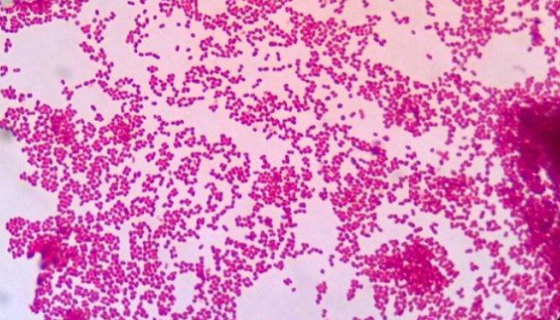
ATCC 14987乙酸钙不动杆菌的形态特征与主要价值！
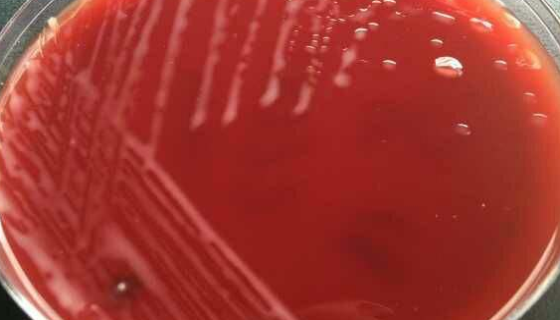
ATCC 12974 带化红球菌的知识解析与产品优势！

大鼠肝星状细胞的主要类型与应用!
大鼠肝星状细胞采用体外多步灌注和密度梯度离心法制备而来,α-...

溶藻弧菌的培养条件与注意事项及打管说明!
溶藻弧菌是Vibrio属的微生物,原产地为中国。非模式菌株。...
酿酒酵母的主要价值与应用方向及相关研究!
酿酒酵母是与人类关系最广泛的一种酵母,用于制作面包和馒头等食...
ATCC 14987乙酸钙不动杆菌的形态特征与主要价值!
乙酸钙不动杆菌是Acinetobacter属的微生物,原产地...

ATCC 23726 具核梭杆菌具核亚种 BIOBW生物
具核梭杆菌具核亚种是指食用菌菌丝体及其生长基质组成的繁殖材料...
ATCC 12974 带化红球菌的知识解析与产品优势!
带化红球菌的知识解析与产品优势。

表皮葡萄球菌的注意事项与保藏方法!
表皮葡萄球菌(Staphylococcus epidermi...

乳酸克鲁维酵母冻干管打管说明书!
乳酸克鲁维酵母是生物技术科学领域非常重要的非酿酒酵母之一,其...

ATCC 13812 白喉棒杆菌 百欧博伟生物
白喉棒杆菌是棒杆菌属的一个种,最初由克列布( E. Kleb...